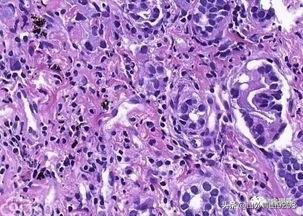

只有癌症才需要做病理检测吗?
说反了,是做了病理之后才确诊的癌症。
病理是诊断的金标准,虽然像CT、超声这些也能诊断肿瘤,但是当和病理诊断有冲突的时候,以病理诊断为准。
身上长了东西切下来之后一般都要送病理检查,因为保不准就是恶性的,所以以防万一,能做病理的都要做。小到脚上长的痣,大到癌症切除后要看到切緣有没有切干净,判断一下肿瘤的类别、性质,为下一步治疗提供参考。
内容仅供参考,如果您需解决具体问题(尤其法律、医学等领域),建议您详细咨询相关领域专业人士。
版权声明:文章内容来源于网络,版权归原作者所有,如有侵权请与我们联系,我们将及时删除。
